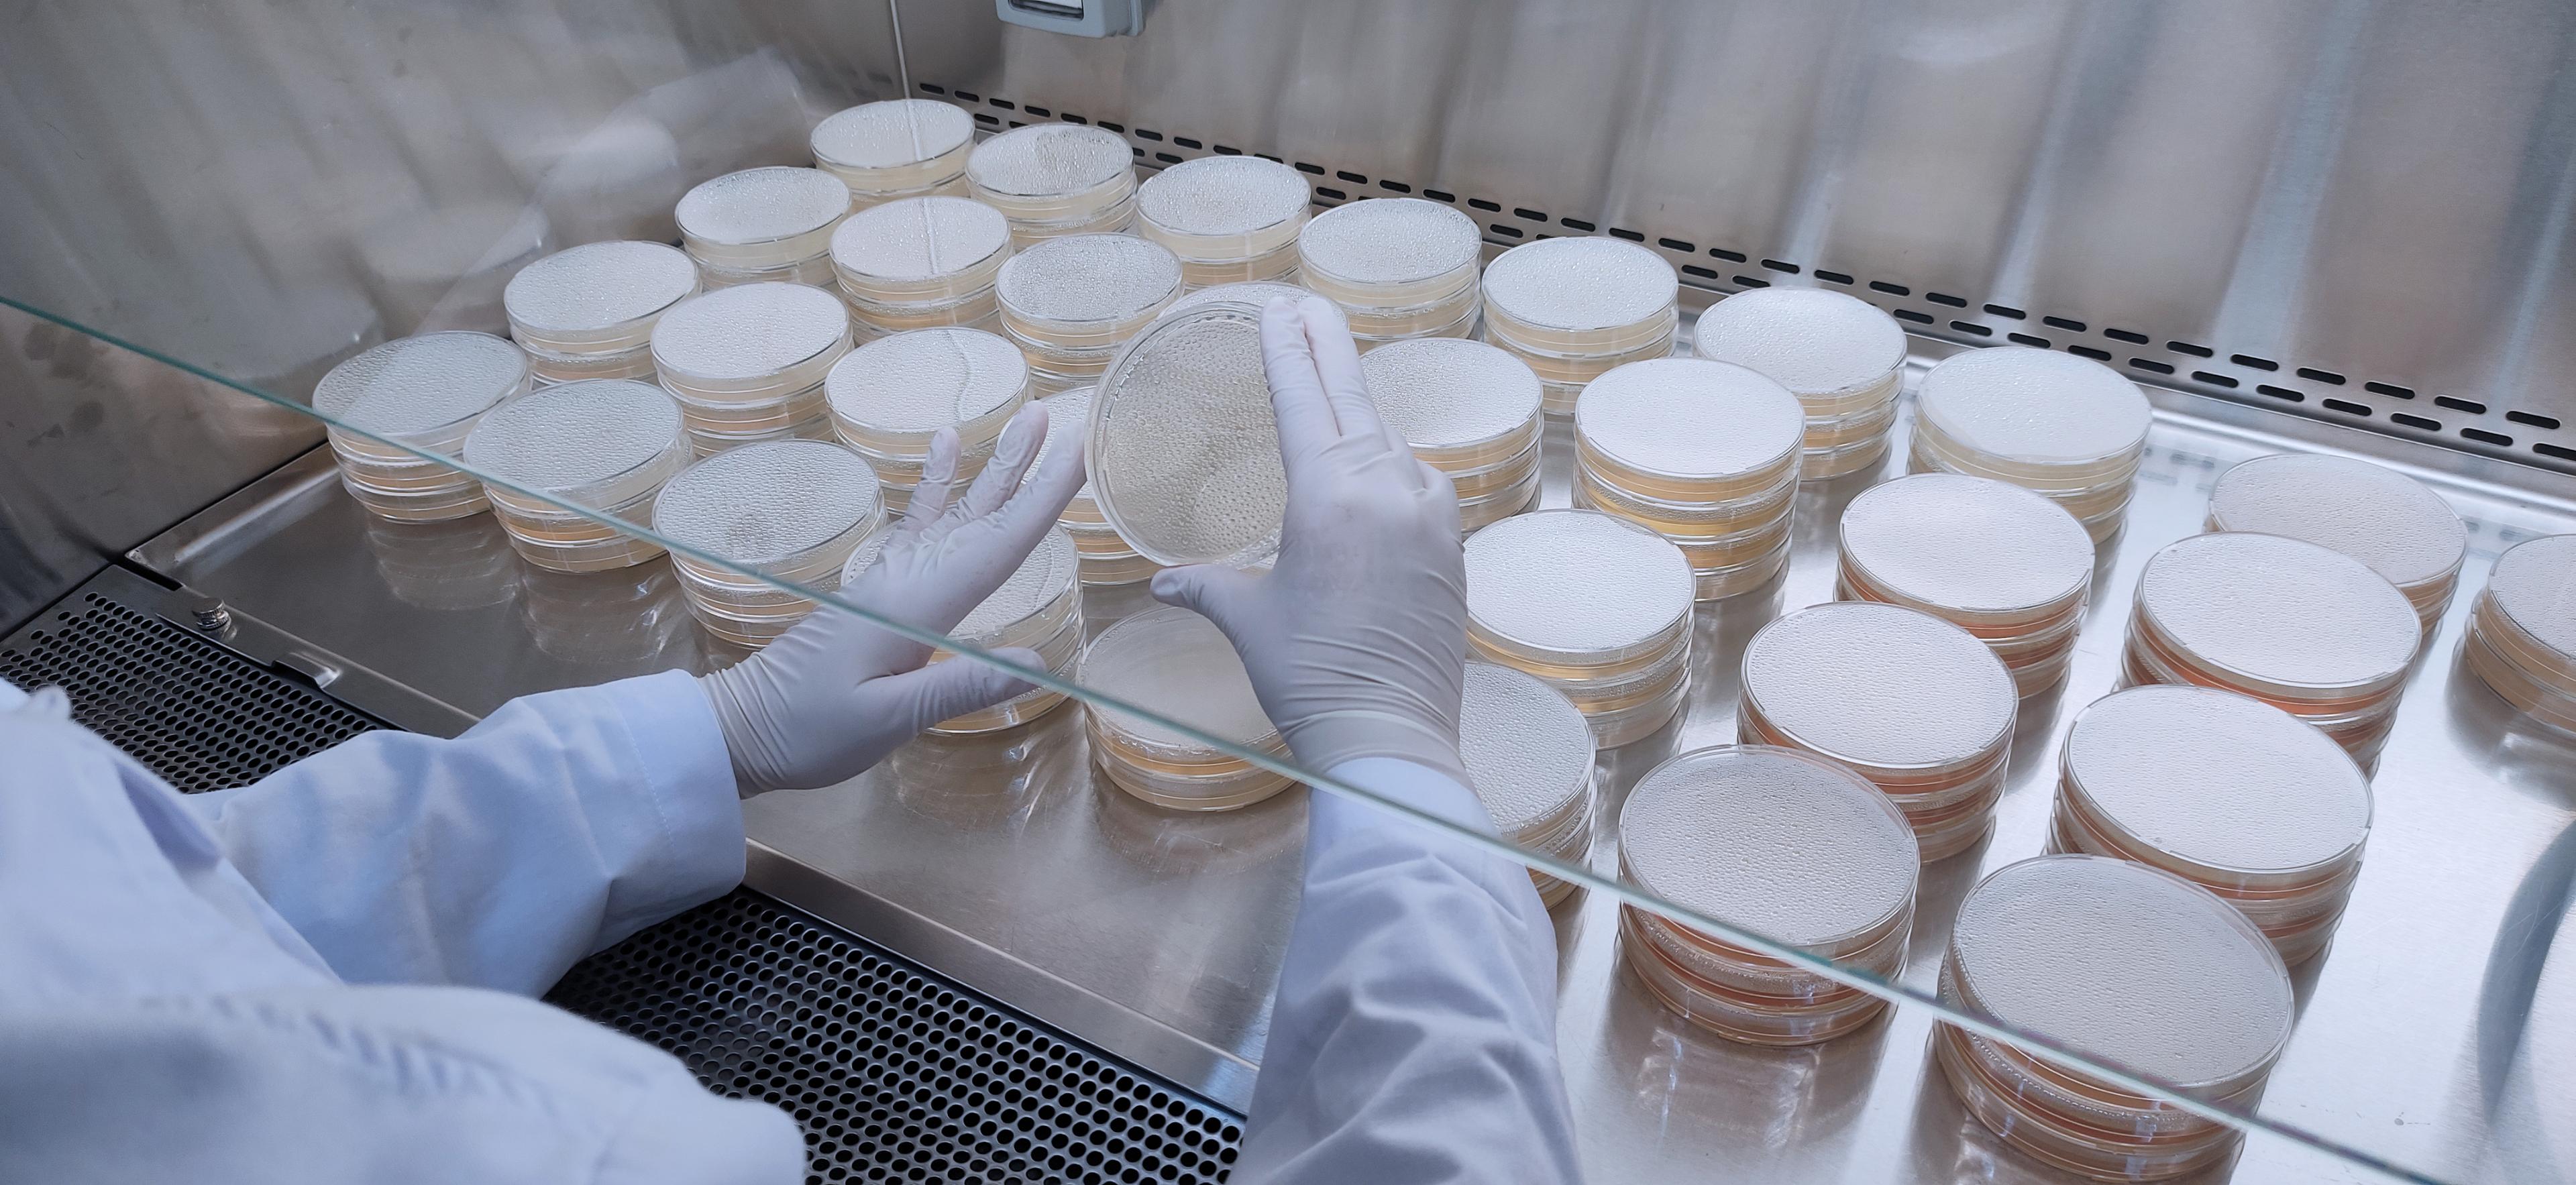

견적 산출부터 시료 접수, 시험 진행, 성적서 발급까지 IT 기술과 자동화 시스템으로
비용과 시간은 줄이고, 정확도는 높인 방부력(보존력) 시험 전문 연구소입니다.

Digital Lab Service
전화나 메일로 일일이 확인하던 번거로움은 이제 없습니다. 온라인으로 진행하여 사정을 관리하고, 데이터를 확인하고 다운로드할 수 있습니다.

Smart Automation
의뢰 접수, 데이터 처리, 그리고 기록은 물론 분석 및 시험 과정 중 자동화할 수 있는 부분을 자동화하였습니다. 불필요한 작업을 줄여 더 빠르고, 더 정확한 시험을 합리적인 비용으로 제공합니다.

Standard Coverage
ISO 11930, USP 51, KS 등 국제 표준 및 국내 규격에 따른 미생물 테스트를 지원하며, 고객사의 니즈에 맞는 커스터마이징 시험법 설계도 가능합니다.

Proven Reliability
숙련된 연구원과 로봇을 통해 시험을 진행합니다. CCTV 와 바코드 기반 관리로 시료의 데이터 이력을 추적하고 자체 개발 AI로 검수합니다.
Scale & Cost
대규모 시험에 특화된 다량 처리 시스템을 통해 비용을 지속적으로 낮춥니다. 품질과 효율성을 모두 잡은 시험을 더 낮은 비용으로 제공합니다.
STEP 1
시료 정보(제품명, pH, 제형, 시험방법)를 입력하면 견적이 자동으로 산출됩니다.
STEP 2
온라인 결제 후 안내된 주소로 시료(150g 이상, 밀봉)를 발송합니다.
STEP 3
금요일까지 도착한 시료는 차주 월요일 시험을 개시합니다.
STEP 4
0day~28day까지 균주별 생존 균수, Log Reduction, 배양 사진을 주차별로 확인하세요.
STEP 5
시험 완료 후 시험 방법 별 기준 판정이 포함된 성적서(PDF)를 다운로드할 수 있습니다.
*소요 기간 : 시료 도착 후 약 35일 이내 (시험 28일 + 데이터 분석/레포트)

불필요한 커뮤니케이션 제로
견적/시험 상황 확인, 성적서 발급을 위해 별도 문의가 필요 없습니다.
실시간 자동 견적
제형, 시험방법, 긴급 여부 선택만으로 견적이 즉시 산출됩니다.
주차별 데이터 공개
0day~28day 균주별 생존 균수, Log Reduction, 배양 사진을 온라인에서 직접 확인할 수 있습니다.
자동 알림 시스템
결제완료, 시료접수, 성적서 발급까지 이메일 알림으로 별도 확인이 필요 없습니다.
재현성 보증 시스템
시험 결과 재현성이 없으면 100% 환불 해드립니다.
내용물 추출이 어려운 제형
AES256 암호화 기술을 활용한 강력한 데이터베이스 데이터 암호화
시험 기초 데이터(Raw Data)는 3년간 보관 후 규정에 따라 파기
시험 데이터 입력, 수정, 삭제 이력을 작업자/일시/변경 내용과 함께 기록
시험 종료 후 1개월 보관 후 전량 폐기합니다. 반환 요청 시 착불 택배로 발송